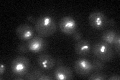
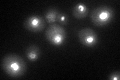

View description
Protein phosphatase required for mitotic exit; located in the nucleolus until liberated by the FEAR and Mitotic Exit Network in anaphase, enabling it to act on key substrates to effect a decrease in CDK/B-cyclin activity and mitotic exit
Localization:
Intensity:
Fold change:
Significance:
-
C’ GFP library in SD
nucleolus32.51 -
N' NOP1pr-GFP in SD

N/A0 -
N' TEF2pr-mCherry in SD

N/A0 -
N' NATIVEpr-GFP in SD

N/A0 -
N' TEF2pr-VC and Cyto-VN in SD

N/A0 -
C’ GFP library in SD+DTT
nucleolus29.30.9No -
C’ GFP library in SD+H2O2

nucleolus37.91.16No -
C’ GFP library in Starvation Media

nucleolus25.520.78No -
C’ GFP library on the background of Pup2-DaMP

nucleolus -
C’ GFP library on the background of CCT mutant

nucleolus42.64871.3113No
